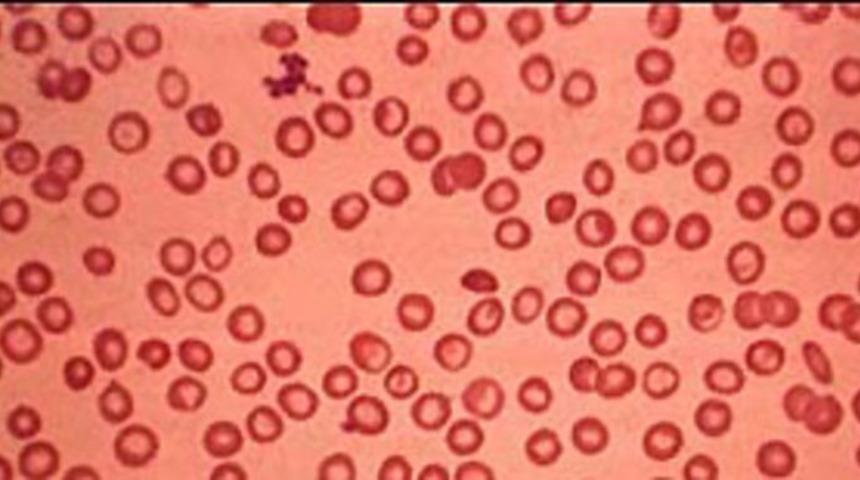
Türkiye'de 4 bin 513 Talasemi hastası var

Akdağ, 8 Mayıs Dünya Talasemi Günü dolayısıyla yaptığı yazılı açıklamada, kalıtsal bir kan hastalığı olan talaseminin Türkiye'de görülme sıklığının yüksek olduğunu belirtti.
Akdağ, Türkiye nüfusunun yüzde 2.1'inin talasemi taşıyıcısı olduğunu ifade etti. Bu oranın bazı bölgelerde yüzde 13'lere çıktığına işaret eden Akdağ, her yıl yüzlerce talasemi hastası bebeğin dünyaya geldiğini anlattı.
Hastalıkla mücadelede, evlenecek çiftlerin evlilik öncesi yaptıracakları testlerin önemli rolü olduğunu kaydeden Akdağ, bu testlerle hastalığın erken dönemde saptanarak önlenebileceğini ifade etti.